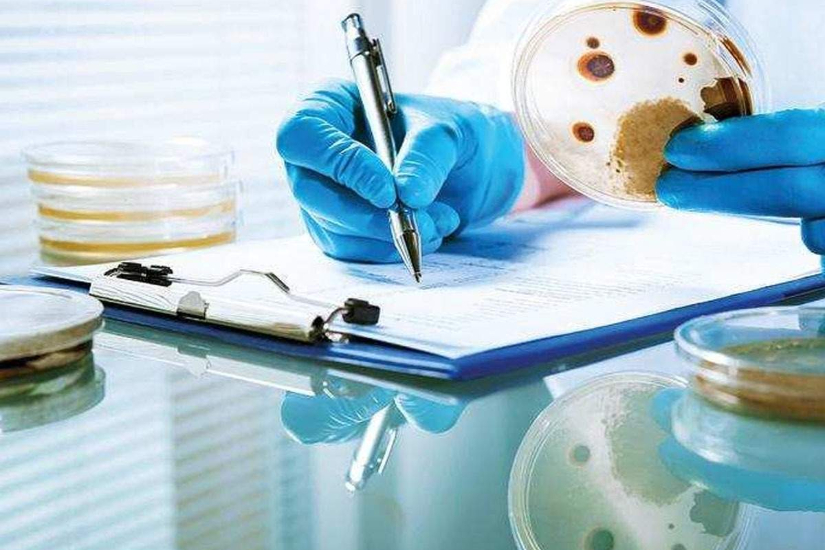

الفطر الأسود والأبيض.. العلامات والأعراض وأكثر الفئات المعرضة لخطر الإصابة
بقلم |
مها محي الدين |
السبت 29 مايو 2021 - 01:03 ص
تم الإعلان مؤخرًا عن الفطر الأسود باعتباره وباءً في أربع ولايات في الهند، ومن ثم بدء الظهور في عدة بلدان أخري، وبعد أسابيع قليلة من قيام الفطر الأسود بإثارة القلق، ظهرت تقارير عن حالات مصابة بالفطريات البيضاء، والتي يقال أنها البيضاء أكثر خطورة من الفطريات السوداء، كما حذر الأطباء من أن التأخير في العلاج من هذه الفطريات يمكن أن يؤدي إلى الوفاة ولذلك يجب التعامل معهم بمنتهى الجدية.
وتجدر الإشارة إلى أن هذه الالتهابات الفطرية ليست جديدة، وكل من الفطريات السوداء والبيضاء ناتجة عن الفطريات المخاطية، الموجودة بالفعل في بيئتنا طوال الوقت، ولكن مع تزايد عدد المصابين بعدوي كورونا أصبحت هذه الفطريات تمثل خطر نظراً إلي أن العدوي تضعف جهاز المناعة تماما أثناء فترة التعافي.
وفيما يلي كل ما تريد معرفته عن الفطريات البيضاء والسوداء، وما يجب الانتباه له، وفقا للحالات التي ظهرت مؤخراً، بحسب ما نشره موقع "تايم اوف إنديا".
كما أن مرضى السكر والأشخاص الذين يعانون من السرطان وأولئك الذين يتناولون العلاج بالستيرويدات لفترات طويلة هم أكثر عرضة للإصابة بالفطريات البيضاء.
وفي بعض الحالات، يمكن أن تؤدي الفطريات أيضًا إلى سعال المرضى بالدم، ويمكن أن تصبح هذه العدوى قاتلة إذا لم تتم معالجتها في الوقت المناسب.
وتجدر الإشارة إلى أن هذه الالتهابات الفطرية ليست جديدة، وكل من الفطريات السوداء والبيضاء ناتجة عن الفطريات المخاطية، الموجودة بالفعل في بيئتنا طوال الوقت، ولكن مع تزايد عدد المصابين بعدوي كورونا أصبحت هذه الفطريات تمثل خطر نظراً إلي أن العدوي تضعف جهاز المناعة تماما أثناء فترة التعافي.
وفيما يلي كل ما تريد معرفته عن الفطريات البيضاء والسوداء، وما يجب الانتباه له، وفقا للحالات التي ظهرت مؤخراً، بحسب ما نشره موقع "تايم اوف إنديا".
الفطر الأبيض
ما يجعل الفطريات البيضاء أكثر خطورة هو حقيقة أن لها تأثيرًا خطيرًا على الرئتين وأجزاء الجسم الأخرى، ويمكن أن تصبح قاتلة لأنها تؤثر بشكل مباشر على الأعضاء الحيوية مثل الدماغ والجهاز التنفسي والجهاز الهضمي.اقرأ أيضا:
تعرف على عدد الخطوات اليومية التي تساعد في الحفاظ على الوزنالفطر الأسود
يمكن أن يؤثر فطر الغشاء المخاطي أو الفطريات السوداء على الوجه والأنف ومحجر العين وحتى الدماغ، ويمكن أن يؤدي إلى فقدان البصر، كما ينتشر إلى الرئتين في بعض الحالات أيضاً.الفطريات البيضاء.. أكثر الفئات المعرضة للخطر
تهاجم الفطريات البيضاء الأشخاص الذين يعانون من نقص المناعة، أي أن مناعتهم ضعيفة، والبيئات غير الصحية التي تحتوي على العفن تجعل الناس عرضة للإصابة بهذه العدوى الفطرية، وهذا المرض ليس معديًا ولكن قد يكون شخصًا آخر يعاني من نقص المناعة معرضًا لخطر العدوي، حيث يمكن استنشاقها من قبل المريض.كما أن مرضى السكر والأشخاص الذين يعانون من السرطان وأولئك الذين يتناولون العلاج بالستيرويدات لفترات طويلة هم أكثر عرضة للإصابة بالفطريات البيضاء.
الفطريات السوداء.. أكثر الفئات المعرضة للخطر
يقال إن مرضى السكر ومرضى فيروس كورونا والأشخاص الذين يستخدمون المنشطات لفترة طويلة هم أكثر عرضة للإصابة بهذه العدوى الفطرية، ويقال إن الإقامة المطولة في وحدة العناية المركزة تزيد من خطر الإصابة بالفطريات السوداء.أعراض الإصابة بالفطريات البيضاء
تتشابه أعراض الفطريات البيضاء إلى حد كبير مع أعراض فيروس كورونا، حيث يمكن أن تتأثر الرئتان وقد تؤدي إلى ألم في الصدر وسعال وضيق في التنفس، ويمكن أن تسبب أيضًا الصداع والآلام والالتهابات أو حتى التورم.أعراض الإصابة بالفطر الأسود
في الأسابيع الأخيرة، تهاجم الفطريات السوداء الأشخاص الذين يتعافون من عدوي كورونا، ويمكن أن تتسبب العدوى في تغير لون الأنف، وعدم وضوح الرؤية، وألم في الوجه من جانب واحد، وآلام في الأسنان، وألم في الصدر وضيق في التنفس.وفي بعض الحالات، يمكن أن تؤدي الفطريات أيضًا إلى سعال المرضى بالدم، ويمكن أن تصبح هذه العدوى قاتلة إذا لم تتم معالجتها في الوقت المناسب.
اقرأ أيضا:
غسول الفم ضرره أكثر من نفعه.. يرتبط بالسرطان ومشاكل القلباقرأ أيضا:
بعيدًا عن التدخين والتعرض للشمس.. عادة شائعة تضيف سنوات إلى وجهك







